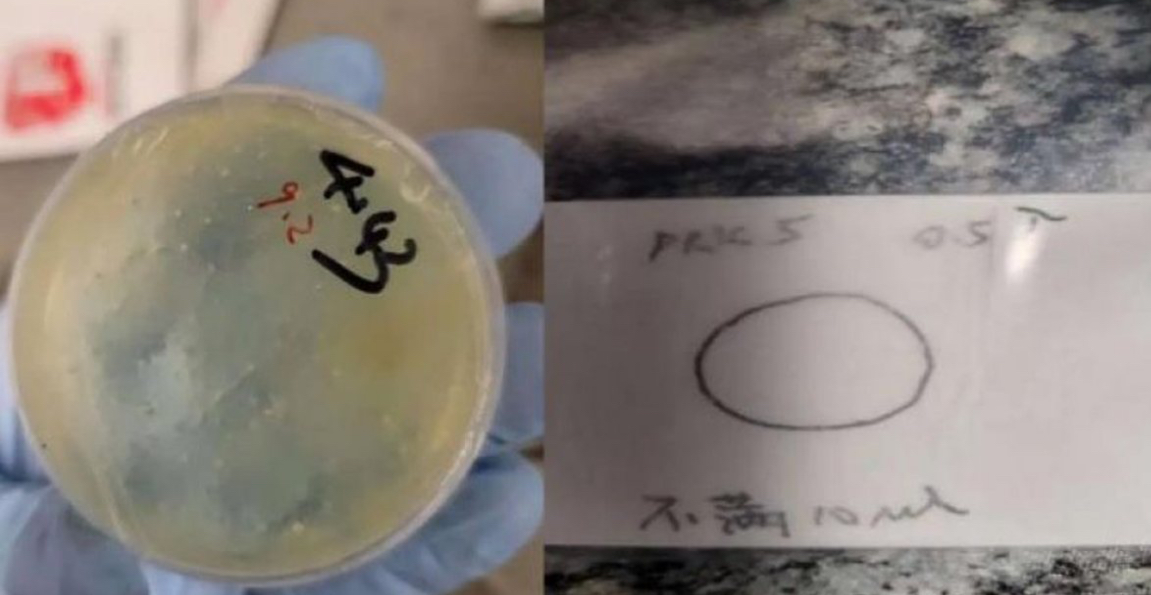

Një shkencëtare kineze është arrestuar pasi akuzohet se ka futur parazitë toksikë kontrabandë në Shtetet e Bashkuara të Amerikës
Chengxuan Han, një studente doktorante në një universitet në Wuhan të Kinës, akuzohet për dërgimin e katër pakove të ndara me “material biologjik të fshehur” tek individë të lidhur me Universitetin e Miçiganit në vitet 2024 dhe 2025, bën të ditur zyra e prokurorit të SHBA-së.
Han është shtetasja e tretë kineze që arrestohet brenda javës së fundit për kontrabandimin e materialeve potencialisht të rrezikshme në këtë universitet.
Policia kufitare zbuloi gjithashtu se përmbajtja e pajisjeve të saj elektronike ishte fshirë tre ditë para mbërritjes në SHBA.
Han u ndalua më 8 qershor pasi zbriti në Detroit, ku u mor në pyetje nga autoritetet kufitare.
Fillimisht, Han gënjeu oficerët duke pretenduar se pakot përmbanin gota plastike dhe jo pjata petri, por më pas pranoi se kishte dhënë “deklarata të rreme” dhe pranoi se pakot përmbanin “material biologjik të lidhur me krimbat parazitë”, sipas prokurorisë amerikane.
Krimbat janë një lloj paraziti që mund të shkaktojë një sërë sëmundjesh tek njerëzit, përfshirë diarrea dhe probleme nervore.
“FBI-ja nuk pranon asnjë tolerancë për ata që shkelin ligjin federal dhe mbetet e vendosur në misionin tonë për të mbrojtur popullin amerikan,” tha Cheyvoryea Gibson, agjente speciale dhe përgjegjëse e zyrës së FBI-së në Detroit.
Kontrabanda e dyshuar e materialeve biologjike nga Chengxuan Han përbën një kërcënim të drejtpërdrejtë për sigurinë publike dhe atë kombëtare, dhe cenon rëndë integritetin e institucioneve kërkimore të vendit tonë.”
Është raportuar se Han i është refuzuar fillimisht viza për SHBA-në në mars, kryesisht për shkak se kishte vështirësi të zhvillonte intervistën në anglisht.
Sipas MailOnline, ajo nuk mundi të përgjigjej në anglisht në pyetje bazë për veten ose fushën e saj të studimeve.
Han aplikoi përsëri dy javë më vonë dhe gjatë intervistës së dytë “foli në mënyrë të besueshme për sfondin e saj arsimor, studimet aktuale dhe planet pasuniversitare,” sipas asaj që raportoi faqja.
Han është shkencëtarja e tretë kineze që akuzohet për krime serioze lidhur me kontrabandimin e materialeve biologjike, shkruan The Telegraph.